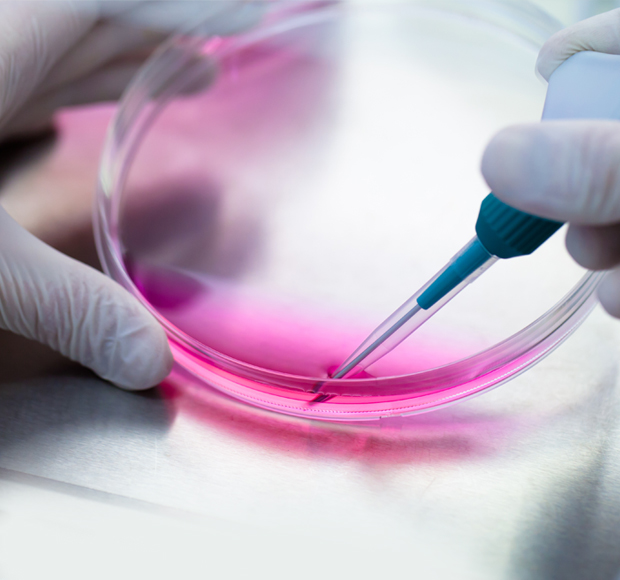

Prendre de la hauteur



Sylvie Russo
Pour nous, créer c’est s’évader,
s’inventer, se surprendre, se libérer
sans perdre de vue le sens.
Sortir des sentiers battus, ne pas se
donner de limite, déborder
d’enthousiasme et d’engagement.
Pour nous, créer c’est répondre avec
pertinence à vos problématiques
de communication.

Jérôme Obringer

Franck-Yves Genevois
Élargir l’horizon
Conseil
Accompagnement
Architecture de
communication
Recommandations
stratégiques

Création
Direction artistique
Concept créatif
Rédaction
Design graphique
Motion Design
Gestion de projet
Exécution Planning
Suivi
Mobilisation de talents
Organisation et gestion
des prestataires externes
Notre expertise
Conception d’identité visuelle, Produits/Marque/Entreprise
-
Campagne de sensibilisation et de mobilisation
- Identité / édition / packaging / publicite web
- exposition / animation de conventions et séminaires / presse d’entreprise / affichage, évènement, film et vidéo
Agence conseil
en communication
Lyon
“C’est une bulle
gonflée de créativité
et d’expérience.”
Envie de
changer d'air ?
Lyon
1 Rue Audran
69001 LYON
Téléphone : 04 78 91 16 43
Strasbourg
34 quai des Bateliers
67000 Strasbourg
“C’est une bulle
gonflée de créativité
et d’expérience.”